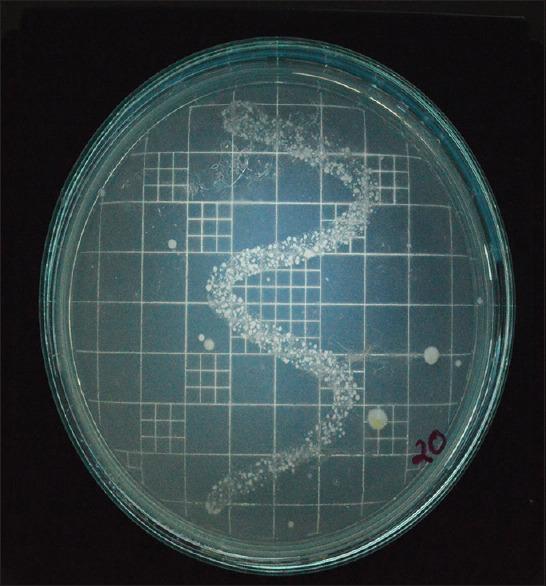
https://cdn.ncbi.nlm.nih.gov/pmc/blobs/829e/7654205/b1cf8c1f44d4/JIPS-20-297-g011.jpg
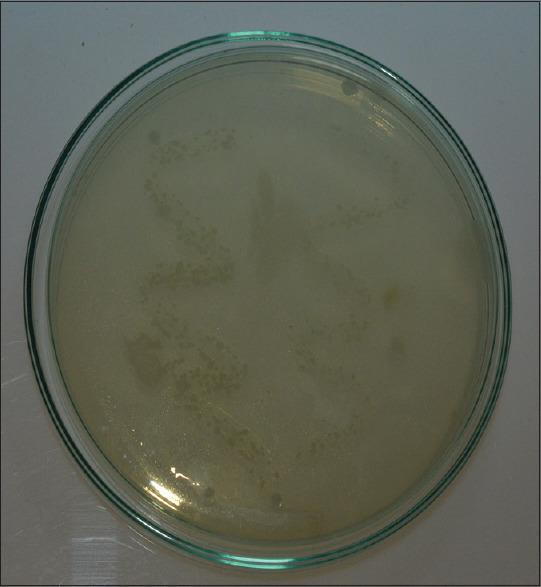
https://cdn.ncbi.nlm.nih.gov/pmc/blobs/829e/7654205/36f25f7cf5a2/JIPS-20-297-g003.jpg
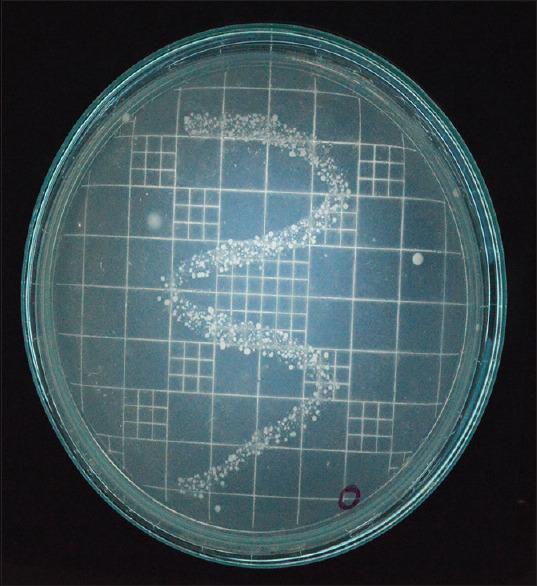
https://cdn.ncbi.nlm.nih.gov/pmc/blobs/829e/7654205/322ca275cc91/JIPS-20-297-g009.jpg

壳聚糖复合不可逆水胶体印模材料抗菌性能的评价
An evaluation of antimicrobial potential of irreversible hydrocolloid impression material incorporated with chitosan.
作者信息
Manikyamba Yenumula J B, Rama Raju A V, Suresh Sajjan M C, Bhupathi P Arun, Rao D Bheemalingeswara, Raju Jampana V V S N
机构信息
Department of Prosthodontics, Vishnu Dental College, Bhimavaram, Andhra Pradesh, India.
出版信息
J Indian Prosthodont Soc. 2020 Jul-Sep;20(3):297-303. doi: 10.4103/jips.jips_50_20. Epub 2020 Jul 17.
AIM
To evaluate the antimicrobial potential of irreversible hydrocolloid impression material manipulated using chitosan impregnated solution at various time intervals.
SETTING AND DESIGN
Evaluative invivo study design.
MATERIALS AND METHODS
Maxillary impressions made for 20 dentulous volunteers using irreversible hydrocolloid impression material manipulated using distilled water as control and using 1% chitosan impregnated solution as test group using stock metal trays with one-week interval. Bacterial samples were collected using dry sterile cotton swab in the mid-palatal region at the time intervals of 0, 10, 20 minutes. Bacterial swabs were inoculated on nutrient agar media and incubated at 37° C for 24 hours. Bacterial colonies were counted with the aid of colony counter.
STATISTICAL ANALYSIS USED
The resultant data was subjected to statistical analysis using repeated measures ANOVA and independent t test.
RESULTS
Adding water soluble chitosan to irreversible hydrocolloid impression material resulted in superior antimicrobial activity. With the passage of time there was a significant decrease in the microbial colony count upto 10min (p=0.016). However, the rate of decrease of microbial colony count was statistically insignificant between the samples collected at 10 and 20 min.
CONCLUSION
Incorporation of water soluble chitosan to irreversible hydrocolloid impression material showed significant antimicrobial activity in 10 minutes.
目的
评估在不同时间间隔使用壳聚糖浸渍溶液处理的不可逆水胶体印模材料的抗菌潜力。
设置与设计
评估性体内研究设计。
材料与方法
为20名有牙颌志愿者制作上颌印模,使用蒸馏水作为对照处理不可逆水胶体印模材料,使用1%壳聚糖浸渍溶液作为试验组,使用标准金属托盘,间隔一周。在0、10、20分钟的时间间隔,使用干燥无菌棉签在上腭中部区域采集细菌样本。将细菌棉签接种在营养琼脂培养基上,于37℃孵育24小时。借助菌落计数器对细菌菌落进行计数。
所用统计分析方法
所得数据采用重复测量方差分析和独立t检验进行统计分析。
结果
向不可逆水胶体印模材料中添加水溶性壳聚糖可产生卓越的抗菌活性。随着时间推移,直至10分钟时微生物菌落计数显著下降(p = 0.016)。然而,在10分钟和20分钟采集的样本之间,微生物菌落计数的下降速率在统计学上无显著差异。
结论
向不可逆水胶体印模材料中加入水溶性壳聚糖在10分钟内显示出显著的抗菌活性。